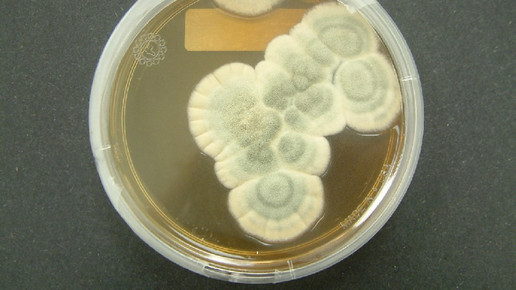
penicillium wikipedia crulina 98 cc by sa 3 0

Lieferengpass: Syphilis-Medikament fehlt
Hunderttausende schwangere Frauen übertragen weltweit den Syphilis-Erreger auf ihr ungeborenes Kind. Viele der infizierten Ungeborenen sterben noch im Mutterleib oder kurz nach der Geburt. Und Neugeborene weisen oft schwere körperliche Entwicklungsstörungen auf. Die sexuell übertragbare Krankheit lässt sich allerdings mit Benzathin-Benzylpenicillin behandeln. Eine einzige Injektion würde Mutter und Kind beschützen. Doch es gibt zahlreiche Länder auf der Welt, wo es zu Lieferengpässen der entsprechenden Arzneimittel kommt.
Brasilien gehört zum Beispiel dazu: Seit zwei Jahren fehlt es regelmäßig in Krankenhäusern an Benzathin-Benzylpenicillin. Den Herstellern fehlt zur Produktion des Antibiotikums der Wirkstoff als Rohsubstanz. Laut brasilianischer Aufsichtsbehörde Anvisa hatten 2014 fünf von sechs Pharmaunternehmen die Produktion entweder auf unbestimmte Zeit oder vorübergehend eingestellt.
Ein Grund war, dass der chinesische Großhändler North China Pharmaceutical Group Semisyntech seine Lizenz verloren hatte. Dabei gibt es weltweit nur vier Unternehmen, die Benzathin-Benzylpenicillin herstellen, berichtet die Süddeutsche Zeitung. So müssen betroffene Frauen auf andere Antibiotika wie Azithromycin, Ceftriaxon und Doxycyclin ausweichen.
Das brasilianische Gesundheitsministerium sagt für dieses Jahr rund 42.000 neue Fälle von Syphilis-Infektionen voraus. Diese Nummer ist 49 Mal höher als noch vor zehn Jahren – von der Dunkelziffer ganz zu schweigen.
Auch wenn die Meldungen von Zika-Infektionen in den vergangenen Monaten nicht abnahmen, ist Syphilis derzeit das größere Problem. Eine von zehn Schwangerschaften endet für den Embryo oder das Kind tödlich, 2013 starben 1160 Kinder an den Folgen der Infektion. Laut Gesundheitsministerium haben sich allein in diesem Jahr mehr als 22.000 Babys infiziert.
Brasilien unternimmt viel, um über sexuell übertragbare Krankheiten aufzuklären. Das Gesundheitsministerium hat beispielsweise die Anzahl der Schnelltests in Krankenhäusern erhöht und die Heilberufler darüber informiert, wie sie Syphilis besser diagnostizieren und therapieren können. Außerdem verschenkt die Regierung zu großen Events wie dem Karneval oder zuletzt während der Olympischen Spiele Millionen Kondome.
Hierzulande war im vergangenen Jahr das Präparat Pendysin vom Lieferengpass betroffen. Infectopharm hatte den Lieferanten für den Wirkstoff gewechselt und kämpfte seit Jahren um die behördliche Genehmigung. Seit August allerdings ist Pendysin laut Hersteller wieder voll lieferfähig. Außerdem steht das wirkstoffgleiche Tardocillin zur Verfügung.
Syphilis-Infektionen haben 2015 in Deutschland einen neuen Höchststand erreicht. Das Robert Koch-Institut (RKI) registrierte 6834 diagnostizierte Fälle. Das sind 19 Prozent mehr als im Vorjahr (5722 Fälle). Vor allem in städtischen Ballungszentren taucht die Krankheit oft auf.
Unbehandelt führt die Syphilisinfektion zu Hautausschlägen und später auch zu Organschäden. Davon kann auch das Gehirn betroffen sein – mit neurologischen Folgen. Heute ist auch bekannt, dass sich Betroffene leichter mit HIV anstecken können.
Syphilis wird durch das Bakterium Treponema pallidum hervorgerufen. Zu den ersten Symptomen zählen Geschwüre im Genitalbereich oder im Mund. Diese sondern eine stark ansteckende Flüssigkeit ab. Bei sexuellen Handlungen kann es so zur Übertragung kommen. Nach dem Abheilen der Geschwüre verläuft die Krankheit in Schüben.

APOTHEKE ADHOC Debatte